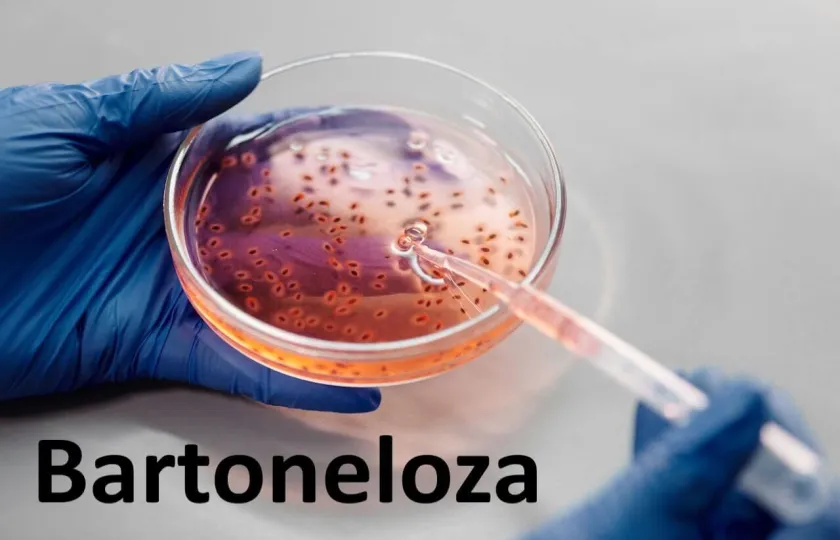
Bartoneloza

Bartoneloza łączy grupę ludzkich chorób wywoływanych przez bakterie tlenowe Gram-ujemne, fakultatywne wewnątrzkomórkowe, które do swojego wzrostu wymagają produktów rozpadu heminy lub erytrocytów.
Pośród gatunków bakterii z rodzaju Bartonella wywołujących choroby u ludzi wymienia się przede wszystkim:
-
Bartonella henselae – wektorem tego gatunku są głównie pchły kocie, a bakterie trafiają do ich odchodów i przenoszą się między zwierzętami oraz ludźmi. Bakteria wnika do ludzkiego organizmu przez przerwane powłoki skóry, np. w wyniku pogryzienia czy podrapania przez kota lub psa, i wywołuje przede wszystkim chorobę kociego pazura (cat scratch disease – CSD).
-
Bartonella quintana – odpowiedzialna za gorączkę okopową, chorobę zakaźną powszechną podczas I i II wojny światowej, gdy bakterie były przenoszone przez wszy ludzkie panoszące się wśród żołnierzy. Obecnie ten rodzaj bartonelozy dotyczy głównie osób bezdomnych oraz innych ludzi żyjących w złych warunkach sanitarnych.
-
Bartonella bacilliformis – wektorem tego gatunku są moskity, a rejonem endemicznym jest Peru. Bakterie B. bacilliformis powodują chorobę Carriona, której pierwsza ostra faza znana jest, jako gorączka Oroya. Śmiertelność nieleczonej choroby Carriona sięga 40%, a jedną z ofiar śmiertelnych był jej odkrywca, Daniel Carrion, który w ramach eksperymentu naukowego wstrzyknął samemu sobie zakażoną krew.
-
Bartonella koehlerae – prawdopodobnym rezerwuarem tego gatunku są koty domowe, a jego wektorem – pchły. Bakterie wywołują u człowieka zapalenie wsierdzia. Inne gatunki odpowiedzialne za tę chorobę to B. elizabethae (pchła szczurza), B. vinsonii subsp. Berkhoffii (kleszcz, pchła), B. vinsonii subsp. Arupensis (kleszcz).
-
Bartonella. grahamii – przenoszona przez pchły, jej rezerwuarem są myszy i nornice. Może wywoływać chorobowe zmiany w obrębie gałki ocznej, np. zapalenie siatkówki i nerwu wzrokowego. Za choroby oczu odpowiadają też B. Quintana, B. elizabethae, B. henselae.